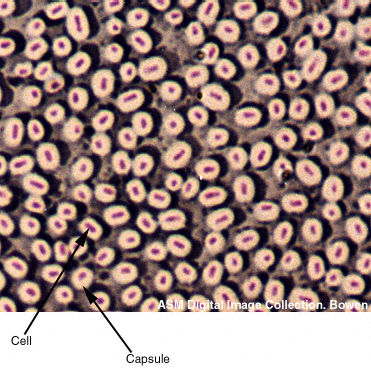
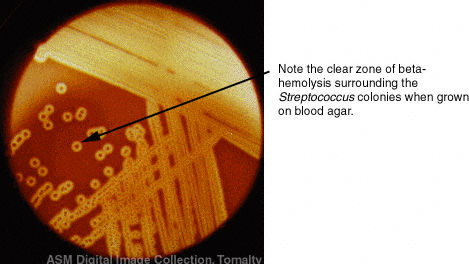

BIO 208 GENERAL MICROBIOLOGY

Spring, 1999
A. General Information
This course is a one-semester survey of microbiology required for Biology majors and minors, dietetics majors, and public health majors.
Meeting Times and Locations: Lectures meet Mon. and Wed. from 11:00-11:50 in Brooks 176. Labs are scheduled for two one hour and twenty minute periods per week in Brooks 129. Each lab section is limited to 18 students -- unfortunately, the course is filled to capacity; as a result it is not possible to attend lab sections other than the one for which you have enrolled unless someone drops and you are able to change sections via the registrar’s office.
Instructor: Dr. Elizabeth Alm
email: Elizabeth.W.Alm@cmich.edu (note: this is the best way to reach me)
Office hours: M 3:30-4:30; T 9:30-12:00, R 9:30-11:00 in Brooks 157. Other times by appointment.
Phone: 774-2503 (with voice mail)
Come to my office hours before you start getting lost by some of the concepts. Don't wait until it's too late!

B. Materials Needed:
C. Reading Assignments:
Reading assignments in the text are listed with the topic outline. Readings and lecture will complement each other. I cannot cover every detail in lecture and will expect you to supplement lectures with certain information from the text. Don’t fall behind. Try to read the assignment before each class, or at the very latest on the same day as class. Reading a text is very different from reading a novel. Keep a pad of paper with you and use it to make outlines, jot down unfamiliar terms, and make other notes to yourself, try to predict what the lecture will cover. Stop frequently and ask yourself "What did I just read?" If you don’t know, then reread the passage. Work with the "Learning Objectives" to focus your attention on the key concepts in each passage and chapter end "Study Questions" to test your reading comprehension. Answers to chapter end study questions will be on reserve in the library and in the Biology resource room.
D. Tests and Grades
Four lecture tests will be given, the lowest of the four lecture tests will be dropped. The final exam will cover the final unit of material in the course as well as a cumulative review of important themes from the entire course. The 4 lecture tests will be given at the CLAS testing center located in the lower level of the Robinson Food Common. Tests will cover both lecture and laboratory material. You will need to bring your CHIP student ID card with you for admission. YOU MAY BE EXCUSED FROM TAKING A TEST AT ITS SCHEDULED TIME ONLY IF YOU'RE ILL (doctors note required) OR FOR DEATH IN THE FAMILY. MAKE-UP TESTS WILL BE GIVEN ONLY FOR EXCUSED ABSENCES AND ONLY ON FRIDAY MAY 7 AND AT NO OTHER TIME IN THE SEMESTER FOR ANY REASON.
Schedule for Tests:
Each test will be available in CLAS on three days, Thurs., Fri., and Sun. except for test 3, which will be available only on Thurs. and Fri. due to Spring Break. You may take the test on any of the three days, whenever you feel ready and it best fits your schedule. Those students with concerns about using the CLAS testing center are encouraged to see me as soon as possible.
1 R 2/4 (9:00-9:00), or F 2/5 (9:00-5:00), or Sun 2/7 (3:00-7:00)
2 R 2/18 (9:00-9:00), or F 2/19 (9:00-5:00), or Sun 2/21 (3:00-7:00)
3 R 3/4 (9:00-9:00), or F 3/5(9:00-5:00)
4 R 4/8 (9:00-9:00), or F 4/9 (9:00-5:00), or Sun 4/11 (3:00-7:00)
Final Exam; Comprehensive; Mon. May 3 10:00-11:50 am; Brooks 176
Grading: Best 3 out of 4 tests 55%
Final comprehensive exam 10%
Laboratory Grade 35%
Grading Scale:
|
A |
A- |
B+ |
B |
B- |
C+ |
C |
C- |
D+ |
D |
D- |
E |
|
93+ |
90- |
87- |
84- |
80- |
77- |
74- |
70- |
67- |
64- |
60- |
0- |
E. Laboratory
The separate lab schedule lists exercises to be done. You should come to lab having read the lab exercise beforehand! You are expected to attend the laboratory section for which you have registered. You must contact your lab instructor prior to an absence if you cannot attend a specific lab. You must bring official documentation if you are missing a lab due to illness or other emergency to facilitate our record keeping and aid in our evaluation. Please do not miss a laboratory unless there is a valid emergency. The laboratory requires intensive preparation and it may not be possible for us to set up a missed laboratory for you at a later time. The laboratory instructors may use their own discretion in allowing make-ups. Any missed lab must be "made up" within 1 week of absence. Failure to follow these guidelines will result in a reduction or forfeiture of points for the missed laboratory exercises. Your grade for the lab will be determined from a combination of quizzes and homework/laboratory assignments. In addition, laboratory material will comprise approximately 50% of each lecture test. You must pass the laboratory portion in order to pass the course.
F. How to succeed in this course.
In order to succeed in this course you should plan to attend all lectures and laboratories, take careful notes, allow ample time to read and study assigned material and turn assignments in on time. You will get more out of lectures if you read the assigned readings before lecture and then reread relevant material carefully soon after lecture.
You should plan on spending a minimum of two hours of study time for each hour of lecture. If you begin to fall behind, make every effort to catch up quickly, otherwise you may find yourself swamped with too much material to assimilate before a test.
Many of you will find attending lectures and labs and reading the text is all the support you will need to do well in the course. Some of you may have problems with some of the material. I offer several forms of assistance to help you with difficulties you may experience.
Learning Assistance for 208
|
TA |
Room Number |
Office Hours |
Phone |
|
Janice Burke |
Br 183 |
T 3:30-5:00; R 9:30-11:00 |
2486 |
|
Jeff Gildow |
Br 184 |
W 10:00-11:00; F 1:00-3:00 |
2485 |
|
Tom Schultz |
Br 132 |
T 9:00-10:00; 1:00-2:00;R 3:00-4:00 |
3279 |
|
Toby West |
Br 184 |
TR 12:30-2:00 |
2485 |
|
Dr. Alm |
Br 157 |
M 3:30-4:30; T 9:30-12:00; R 9:30-11:00 |
2503 |
Schedule of Learning Assistance for 208
|
|
M |
T |
W |
R |
F - Open Lab Day |
|
9-9:30 |
|
Tom |
|
|
|
|
9:30-10 |
|
Tom/Dr. Alm |
|
Dr. Alm/Janice |
|
|
10-10:30 |
|
|
Jeff |
Janice |
|
|
10:30-11 |
|
Dr. Alm |
|
|
|
|
11-11:30 |
Lecture |
|
Lecture |
|
Study Session |
|
11:30-12 |
Br 176 |
|
Br 176 |
|
Br 148 |
|
12-12:30 |
|
|
|
|
|
|
12:30-1 |
|
Toby |
|
|
|
|
1-1:30 |
|
Toby/Tom |
|
Toby |
|
|
1:30-2 |
|
Toby/Tom |
|
|
Jeff |
|
2-2:30 |
|
|
|
|
|
|
2:30-3 |
|
|
|
|
|
|
3-3:30 |
|
|
|
Tom |
|
|
3:30-4 |
Dr. Alm |
|
|
|
|
|
4-4:30 |
|
Janice |
|
|
|
|
4:30-5 |
|
|
|
|
|
TENTATIVE LECTURE SCHEDULE
|
Date |
Lecture Topic |
Reading in Tortora, Funke & Case |
Supplemental Web Sites |
|
W 1/13 |
Unit 1. The Microbial World and You CH 1: What Are Microbes? What is Microbiology? |
pp. 2, 14-22 |
|
|
M 1/18 |
CH 1: How Did Microbiology Become a Science? |
pp. 3-14; 398-399 |
|
|
W 1/20 |
Classification of Microbes / CH 3: How Do We See Microbes? |
pp. 268-274 / pp. 56-64 |
|
|
M 1/25 |
CH 4: Anatomy of Prokaryotic Cells |
pp. 88-98 |
|
|
W 1/27 |
continued |
pp.76-88, 68-72 |
|
|
M 2/1 |
End Material For Test 1 |
pp. 98-107 |
|
|
W 2/3 |
Unit 2. How Do Microbes Grow? |
pp. 169-177 |
|
|
R, F, S |
TEST 1 – Unit 1 |
|
|
|
M 2/8 |
CH 6: Effects of the Physical Environment on Microbial Growth |
pp.154-162 |
|
|
W 2/10 |
CH 7: Control of Microbial Growth |
CH 7: entire |
|
|
M 2/15 |
Microbial Nutrition / End Material for Test 2 |
Handout |
|
|
W 2/17 |
Unit 3. What Enables Microbes to Thrive? CH 5: General characteristics of metabolism, enzymes, redox |
pp. 112-122 |
|
|
R, F, S |
TEST 2 – UNIT 2 |
|
|
|
M 2/22 |
CH 5: Carbohydrate catabolism |
pp. 122-125 |
|
|
W 2/24 |
CH 5: Fermentation / Aerobic Respiration |
pp. 132-134/125-130 |
|
|
M 3/1 |
CH 5: Anaerobic Respiration / Autotrophy |
pp. 130-132/136-142 |
|
|
W 3/3 |
CH 5: Anabolism / End Material for Test 3 / Review |
pp. 142-146 |
|
|
R, F |
TEST 3 – UNIT 3 |
|
|
|
3/6-14 |
Spring Break |
|
|
|
M 3/15 |
Unit 4. Microbial Genetics and Viruses CH 8: Nucleic Acids in Prokaryotes / DNA Replication |
pp. 48-51/205-211 |
|
|
W 3/17 |
CH 8: Transcription and Translation / Gene Regulation in Prokaryotes |
pp. 211-215/215- 221 |
|
|
M 3/22 |
CH 8: Change in Genetic Information / Genetic Transfer |
pp. 221-226/229-237 |
|
|
W 3/24 |
CH 13: Viruses - General Characteristics and Bacteriophages |
pp. 359-373 |
|
|
M 3/29 |
CH 13: Viruses - Animal Viruses |
pp. 373-382 |
|
|
W 3/31 |
CH 9: Biotechnology End Material for Test 4 |
CH 9: entire |
|
|
M 4/5 |
Unit 5. Survey - Role of Microbes in Health and Disease CH 11: Bacteria, Protozoa, Fungi - introduction |
CH 11: entire (skim); pp. 320-330; 339-344 |
|
|
W 4/7 |
CH 27: Environmental Microbiology |
CH 27: entire |
|
|
R, F, S |
TEST 4 – UNIT 4 |
|
|
|
M 4/12 |
CH 28: Applied and Industrial Microbiology |
CH 28: entire |
|
|
W 4/14 |
CH 21: Important microbial diseases of the skin; CH 22: nervous system; CH 23: cardiovascular and lymphatic systems |
pp. 558-564, 567-572; 580-587, 590-592, 594; 602-603, 607-608, 609-611, 616-622 |
|
|
M 4/19 |
CH 24: Important microbial diseases of the respiratory system |
pp. 631-633, 637-642, 646-648 |
|
|
W 4/21 |
CH 26: Important sexually transmitted diseases |
pp. 692-694, 696-704, 705-706, 519-526 |
|
|
M 4/26 |
CH 25: Important microbial diseases of the digestive system; food poisoning / The threat of biological warfare |
pp. 658-659, 622-666, 673-677, 678-679 |
|
|
W 4/28 |
Where is Microbiology Going in the 21st Century? |
|
|
|
M 5/3 |
Final Exam - Comprehensive 10:00-11:50 Brooks 176 |
|
TENTATIVE LABORATORY SCHEDULE
|
Date |
|
|
January W, R 13, 14 |
Laboratory Check-in. Unit 1. Exercise 1. |
|
M, T 18, 19 |
Finish Exercise 1. Start Exercise 2. |
|
W, R 20, 21 |
Finish Exercise 2 and collect report pages for Exercises 1 and 2. Start and complete Exercise 3. |
|
M, T 25, 26 |
Quiz 1 Labs 1-4. Collect Exercise 3. Start and complete Exercise 4. |
|
W, R 27, 28 |
Collect Exercise 4. Start, complete, and collect Exercise 5. |
|
February M, T 1, 2 |
Start and complete Exercise 6. TAs ü Exercise 6 but will not collect. All graded exercises will be returned. End Material For Test 1 (covers labs 1-6). |
|
W, R 3, 4 |
Unit 2. Start Exercise 7. |
|
M, T 8, 9 |
Complete and collect Exercise 7. |
|
W, R 10, 11 |
Start Exercise 9. |
|
M, T 15, 16 |
Quiz 2 Labs 5,6,7,9. Complete Exercise 9. End Material for Test 2 (covers labs 5,6,7,9). |
|
W, R 17, 18 |
Unit 3. Start Exercise 10, swab M-H plates. |
|
M, T 22, 23 |
Complete Exercise 10. Start Exercise 8 - Inoculate Enterotube II only - 1 per group. |
|
W, R 24, 25 |
Continue Exercise - Interpret Enterotube II, Inoculate IMViC test media. |
|
March M, T 1, 2 |
Complete and collect Exercise 8. Start Exercise 19. |
|
W, R 3, 4 |
Complete Exercise 19. TAs ü Exercise 19 but will not collect. All graded exercises returned. End Material For Test 3 (covers labs10, 8, and 19). |
|
6-14 |
Spring Break |
|
M, T 15, 16 |
Unit 4. Start and complete Exercise 11. Start Exercise 12 (pour gels). |
|
W, R 17, 18 |
Complete Exercise 12. |
|
M, T 22, 23 |
Collect Exercise 11 and 12 (1 report page). Start Exercise 13. |
|
W, R 24, 25 |
Complete and collect Exercise 13. Start Exercise 14. |
|
M, T 29, 30 |
Quiz 3 Labs 11-14. Complete and collect Exercise 14 (returned W,R). All other graded exercises returned. End Material for Test 4 (covers Labs 11-14). |
|
April W, R 31, 1 |
Unit 5. Start Exercise 15. |
|
M, T 5, 6 |
Complete Exercise 15. Start Exercise 16. |
|
W, R 7, 8 |
Continue Exercise 16, collect Part A. Collect Exercise 15. |
|
M, T 12, 13 |
Quiz 4 Labs 15-17. Continue Exercise 16. Start Exercise 17. |
|
W, R 14, 15 |
Complete and collect Exercise 16 Part B. Continue Exercise 17. Start Exercise 18. |
|
M, T 19, 20 |
Complete and collect Exercise 18. Start Exercise 20. |
|
W, R 21, 22 |
Complete and collect Exercise 20. Complete and collect Exercise 17. |
|
M, T 26, 27 |
Start Exercise 21. |
|
W, R 28, 29 |
Complete and collect Exercise 21. Laboratory check-out. All graded exercises can be picked up at your TAs office Friday April 30. |
|
M May 3 |
FINAL EXAM - COMPREHENSIVE. 10:00- 11:50 am in Brooks 176 |

Some fun and useful websites to help you learn more about the topics covered in this course, click
HERE!!